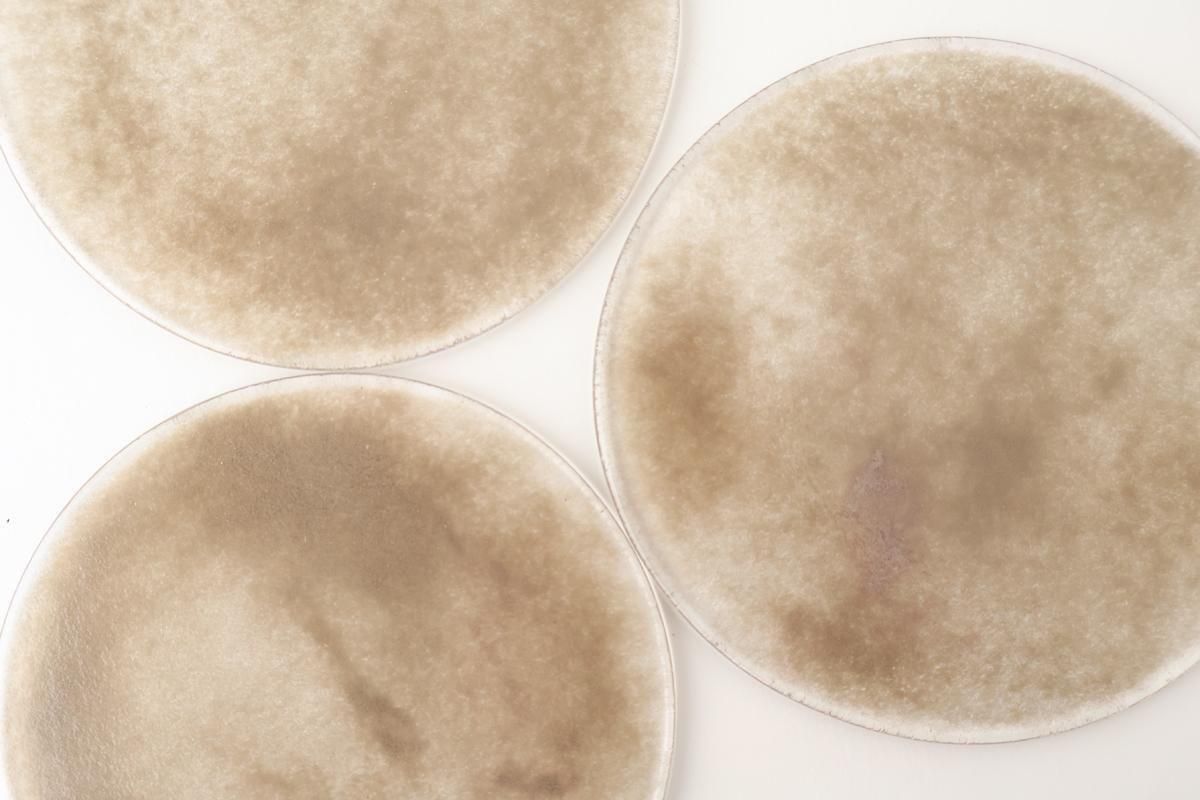

見惚れる美しさ
使う面によって表情の変わる、ガラスのプレートです。
片面はガラス粒によるざらりとした手触りで、もう片面はつるりとした手触り。
どちらの面も使うことができるので、気分に合わせて使い分けすることができます。
優しい表情のグレーは、まるで幻想的な風景のよう。
シンプルなフォルムながら、唯一無二の存在感があるプレートです。
普段使いから、おもてなしまで
カルパッチョやカプレーゼなど、ちょこんとのせるだけでレストランのような雰囲気に。
いつもの簡単な副菜も、なんだか特別感を感じる一皿になります。
アップルパイにアイスクリームをトッピングしたら、至福のおやつタイム。
インテリアとして、ネックレスやピアスなどを置いても素敵ですね。
| サイズ | 径 約14.0〜16.0cm 高さ 約0.5cm |
|---|
| 重さ | 約238g |
|---|
| 素材 | ガラス |
|---|
電子レンジ 食洗機 | 電子レンジ × 食洗機 × |
|---|
直火 オーブン | 直火 × オーブン × |
|---|
作家さんのおすすめメンテナンス | ・手洗いと手拭きをお勧めします。 ・長い間使用しないと、曇りや汚れがでてきます。定期的に洗い、柔らかい布で拭いてください。 |
|---|
商品特性/ 取扱注意点 | ・耐熱ガラスではありませんので、急激な温度変化や強い衝撃で割れることがあります。 ・重ねるとキズがつく場合がございます。気になる方は布や紙を挟むなどしてください。 ・色ガラスについている鉄粉が付着することがあります。制作時に気を付けて取り除いておりますが全てではありません。 ・泡やミャクリと呼ばれるスジが入っていることがあります。これらはガラスの揺らぎや柔らかさを感じるものとして良品としています。 ・泡やミャクリが入っていてもご使用には問題ありません。 ・ひとつひとつ違った表情をみせる、手作りならではのあたたかみのある風合いを楽しみたい方におすすめです。 ・作家・窯元によって、価格の見直し・改定が行われる場合がございます。 |
|---|
ご購入前に知っていただきたいこと
吹きガラスのうつわは、フォルムや気泡の現れかたが違ったりと、個性豊かな味のある表情。
ひとつひとつ異なり、全く同じものがないところが魅力です。
これらも手仕事のうつわの個性として、「一期一会」な出会いを楽しんでくださいね。
【個体差】

手づくりのため、形や大きさ、厚みには個体差があります。
【模様】
柄や模様のあらわれ方には、それぞれ違いがみられます。
【その他のご注意】
〇制作の過程でできる、鉄粉や気泡が見られる場合がございます。
〇窯元や作家さんの検品を通過した商品を再度検品し、お客さまのもとへお届けしています。
■詳しくは、こちらをご覧ください。
うつわの特性と、購入の際にご理解いただきたいこと
シリーズ展開について
■その他、一覧ページです。
FUKU glassworks 相馬佳織 一覧ページ
■ガラスのうつわは、こちらからもご覧いただけます。
お気に入りを見つけてくださいね。
ガラスのうつわ 一覧ページ
FUKU glassworks 相馬佳織
青森県青森市出身/長野県長野市在住
2004 秋田公立美術工芸短期大学 窯芸硝子研究科
2004〜 ガラス工房 橙スタッフ
2015 フリーランスとして制作活動開始
2016 FUKU glassworksを構える
2018 アトリエ移転・実店舗FUKU tenpo OPEN
生活に寄り添い、美しく佇むガラス。
何気ない輝きで暮らす空間をともに彩っていく
そんなガラスでありたいと思っています。